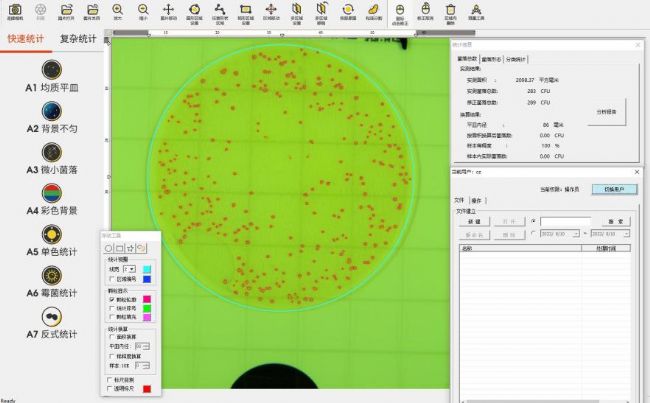

菌落總數(shù)測定是用來判定食品被細(xì)菌污染的程度及衛(wèi)生質(zhì)量,它反映食品在生產(chǎn)過程中是否符合衛(wèi)生要求,以便對被檢樣品做出適當(dāng)?shù)男l(wèi)生學(xué)評價(jià)。菌落總數(shù)的多少在一定程度上標(biāo)志著食品衛(wèi)生質(zhì)量的優(yōu)劣,如果食用了菌落總數(shù)超標(biāo)的食品,輕則會引起腹瀉,重則可能會引起食物中毒。

檢測食品中微生物數(shù)量,一般采用標(biāo)準(zhǔn)平板菌落計(jì)數(shù)法對食品中的活的微生物進(jìn)行菌落形成單位數(shù)量的檢測,即將部分樣品取出混合均勻,用適當(dāng)?shù)南♂屢哼M(jìn)行梯度稀釋,取一定量的稀釋液涂布或傾注瓊脂平板,在合適的溫度下培養(yǎng)一定的時(shí)間,然后通過肉眼觀察或電子計(jì)數(shù)器對所有可見菌落進(jìn)行計(jì)數(shù)。

GB 4789.2-2016《食品安全國家標(biāo)準(zhǔn) 食品微生物學(xué)檢驗(yàn) 菌落總數(shù)測定》
GB 4789.2-2016中提到,在對樣品進(jìn)行處理和培養(yǎng)后,就可對各平板進(jìn)行計(jì)數(shù),可用肉眼觀察,必要時(shí)可借助放大鏡或菌落計(jì)數(shù)器,記錄稀釋倍數(shù)和相應(yīng)的菌落數(shù)量。

菌落計(jì)數(shù)在完成培養(yǎng)后應(yīng)立即進(jìn)行,以防細(xì)菌繼續(xù)生長蔓延影響實(shí)測結(jié)果。菌落比較小且密集,由于視力疲勞、菌落難以辨認(rèn)或計(jì)數(shù)過程中被打擾等問題,均可出現(xiàn)計(jì)數(shù)誤差,導(dǎo)致錯誤結(jié)果,影響實(shí)驗(yàn)進(jìn)度。“這個(gè)菌我數(shù)過了嗎?”“我數(shù)到多少了?”

為了解決在菌落計(jì)數(shù)環(huán)節(jié)中易出現(xiàn)的難計(jì)數(shù)、重復(fù)計(jì)數(shù)等問題,近日,杭州大微推出兩款專門應(yīng)用于菌落計(jì)數(shù)環(huán)節(jié)的自動化儀器。
DW-2系列 菌落計(jì)數(shù)器:

儀器為數(shù)顯式半自動細(xì)菌檢驗(yàn)儀器,塑料平皿和玻璃平皿均可適用。儀器采用感應(yīng)壓力計(jì)數(shù)系統(tǒng),每次計(jì)數(shù)均有蜂鳴器提示,如有遺漏,還可用手動計(jì)數(shù)鍵補(bǔ)計(jì)調(diào)整。
雖然半自動菌落計(jì)數(shù)器在計(jì)數(shù)記錄、計(jì)數(shù)標(biāo)記、菌落“放大”等方面減小了菌落計(jì)數(shù)的人工操作壓力,但無法完全實(shí)現(xiàn)全自動菌落計(jì)數(shù)。因此杭州大微在此基礎(chǔ)上研究開發(fā)出了全自動菌落計(jì)數(shù)儀。
DW-V系列 全自動菌落計(jì)數(shù)儀:

DW-V系列全自動菌落計(jì)數(shù)儀用于對微生物菌落進(jìn)行快速讀數(shù)和統(tǒng)計(jì),全自動運(yùn)行,無需人工干預(yù),結(jié)果準(zhǔn)確,能夠明顯提高統(tǒng)計(jì)效率,適用于各類平板及測試片,支持多種菌落形態(tài)的自動統(tǒng)計(jì)。

菌落總數(shù)測試實(shí)驗(yàn):以大腸桿菌為實(shí)驗(yàn)對象,通過測試片法和平板法的結(jié)果比對,驗(yàn)證DW-V9型全自動菌落計(jì)數(shù)儀在測試片計(jì)數(shù)方面的性能和準(zhǔn)確性。

實(shí)驗(yàn)結(jié)果:經(jīng)兩種方法培養(yǎng)后所得到的大腸桿菌的菌液濃度結(jié)果接近,在一個(gè)數(shù)量級上;測試片法人工計(jì)數(shù)和儀器計(jì)數(shù)兩種方法的菌落計(jì)數(shù)結(jié)果稍有差異,但最終計(jì)算結(jié)果相同,都為3.0×109 CFU/mL。
實(shí)驗(yàn)結(jié)論:說明DW-V9能夠應(yīng)用于菌落總數(shù)測試片法,滿足GB 4789.2-2022《食品安全國家標(biāo)準(zhǔn) 食品微生物學(xué)檢驗(yàn) 菌落總數(shù)測定》,并能準(zhǔn)確計(jì)數(shù)菌落總數(shù)。
產(chǎn)品優(yōu)勢:
一鍵完成菌落計(jì)數(shù),統(tǒng)計(jì)平板上所有菌落僅需1秒;

2、重復(fù)度高
計(jì)數(shù)結(jié)果標(biāo)準(zhǔn)化且重復(fù)度高;

3、模式多樣
支持不同類型平板,多種模式可供選擇;

獨(dú)特的萊茵伯格照明系統(tǒng)可對菌落進(jìn)行無損著色,提高計(jì)數(shù)準(zhǔn)確性;
